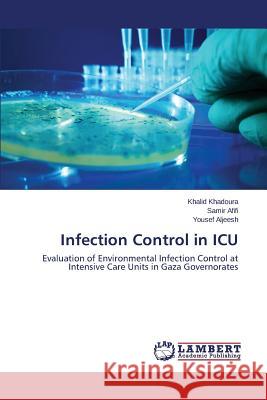
Infection Control in ICU Khadoura Khalid 9783659345272 LAP Lambert Academic Publishing - książka

Infection Control in ICU » książka
Infection Control in ICU
ISBN-13: 9783659345272 / Angielski / Miękka / 2015 / 212 str.
Worldwide, many lives are lost because of the spread of infections in health facilities. Microbial organisms spreading in everything around us (air, water, food and inanimate surfaces). Most of these infections can be prevented by well-established processes for decontamination and cleaning of soiled instruments. This study aimed to evaluate the environmental infection control (EIC) measures in the general ICUs in Gaza. A total of 196 microbiological samples for air, water, and inanimate surfaces were surveyed. Both ambient air and inspiratory air from mechanical ventilator machines were sampled and cultured for bacterial and fungal count. Also, 20 water specimens were tested for bacterial presence. In addition, 120 swabbed cultures from surfaces and equipments were growing in a pre-enrichment media before incubation. Moreover, a total of 516 reading for climate temperature and relative humidity were gathered as the most important factors assist in bacterial multiplication. Self-administered questionnaire was fulfilled by 73 health care providers (HCPs) to assess the knowledge and attitude toward EIC. Furthermore, 68 HCPs practices were evaluated through an observation checklist.
Worldwide, many lives are lost because of the spread of infections in health facilities. Microbial organisms spreading in everything around us (air, water, food and inanimate surfaces). Most of these infections can be prevented by well-established processes for decontamination and cleaning of soiled instruments. This study aimed to evaluate the environmental infection control (EIC) measures in the general ICUs in Gaza. A total of 196 microbiological samples for air, water, and inanimate surfaces were surveyed. Both ambient air and inspiratory air from mechanical ventilator machines were sampled and cultured for bacterial and fungal count. Also, 20 water specimens were tested for bacterial presence. In addition, 120 swabbed cultures from surfaces and equipments were growing in a pre-enrichment media before incubation. Moreover, a total of 516 reading for climate temperature and relative humidity were gathered as the most important factors assist in bacterial multiplication. Self-administered questionnaire was fulfilled by 73 health care providers (HCPs) to assess the knowledge and attitude toward EIC. Furthermore, 68 HCPs practices were evaluated through an observation checklist.